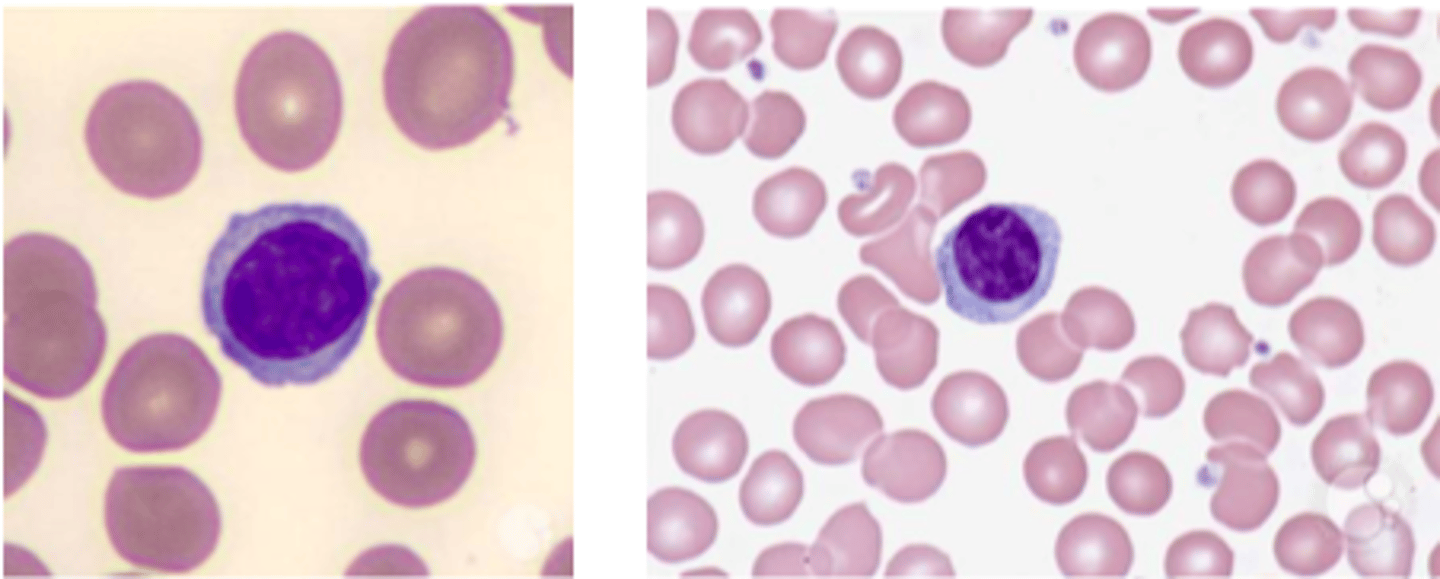
<p>Hvilende B celler og t celler forekommer som små lymfocytter i G0 fase, hvor de ikke deler sig.</p><p>Hvis lymfocytten reagerer med et antigen, så kan den modtage nok signaler til at udvikle sig til en celle med mere cytoplasma.</p>

6. Aktivering af T lymfocytter
1/47
There's no tags or description
Looks like no tags are added yet.
Name | Mastery | Learn | Test | Matching | Spaced |
|---|
No study sessions yet.
48 Terms
Hvilke forskellige subpopulationer findes der af T celler?
CD4+ T celler
-Th1 celler
-Th2 celler
-Th17 celler
-nTreg
-iTreg
CD8+ celler
NKT Celler
Memory T celler
-Effektor memory celler
-Centrale memory celler
Beskriv lymfocytter
Hvilende B celler og t celler forekommer som små lymfocytter i G0 fase, hvor de ikke deler sig.
Hvis lymfocytten reagerer med et antigen, så kan den modtage nok signaler til at udvikle sig til en celle med mere cytoplasma.
Beskriv T cellerne
Udgør 55-85% af de lymfoide celler i blodet.
De skal modnes i thymus før de bliver funktionsdygtige.
Hvad udviser modne T celler på deres overflade?
TCR, CD3 samt enten CD4+ eller CD8+ der kan binde til MHC I og II
Hvilke celler ses der flest af i kroppen?
Der ses dobbelt så mange CD4+ som der ses CD8+
Hvad er CD4+ T celler?
Det er hjælper celler.
De virker aktiverende og opregulerende på en lang række immunreaktioner.
De hjælper i høj grad gennem deres produktion af cytokiner.
Beskriv CD8+ T celler
De fleste celler der udtrykker CD8+ kan udvikle sig til cytotoksiske celler, som dræber målceller der har MHC I bundet til sig.
De udskiller og secernerer også cytokiner.
Beskriv gamma-delta T cellerne
5-10% af kroppens T celler bærer gamma delta på deres TCR.
De findes hovedsageligt i lymfoide væv og epithel.
De udtrykker ikke CD4 eller CD8.
De kan også være cytotoksiske og dræbe virus eller cancerinficerede celler.
Beskriv NKT cellerne
De genkender ikke MHC I og II, men CD1d der er en form for MHC I.
De har hellemarkørerne CD16, CD56 og TCR på deres overflade.
De er med til at regulere immunforsvaret igennem deres cytokin produktion.
Hvilke typer af antigenpræsenterende celler (APC) findes der?
1. Dendritiske celler
2. B celler
3. Makrofager
Hvad er APC'ernes rolle i det adaptive immunforsvar?
De spiller en vigtig rolle i det at deres primære opgave består af at optage antigener og behandle dem, og derefter præsentere dem for T-lymfocytter.
Dette er afgørende for igangsættelse og regulering af specifikke immunrespons.
Beskriv de dendritiske celler som APC
De er de mest potente APC'er.
De aktivere:
- Naive T celler
-Effektor T celler
-Memory T celler
Modne findes i lymfeknuder og milt.
Umodne findes i det perifere væv.

Beskriv makrofagerne som APC
De starter som monocytter i blodet og kan differentiere til makrofager i vævet.
Hovedfunktionen er fagocytose, drab og nedbrydning af ødelagte celler og mikroorganismer.
De kan præsentere MHC II til T celler.
De aktivere:
- Effektor T celler
- Memory T celler
Beskriv B celler
De findes primært i de sekundære lymfoide organer.
De udtrykker MHC II
De er effektive APC'er, især for opløselige antigener der kan genkendes af BCR
De aktiverer:
-Naive T celler
-Effektor T celler
-Memory T celler
Hvorfor er det vigtigt at Th celler bliver aktiveret?
Th celler skal aktiveres, for at kunne få Tc celler og B celler til at differentiere.
Beskriv overordnet hvordan Th og Tc celler bliver aktiveret:
Signal 1: Antigengenkendelse
Signal 2: Kostimulation
Signal 3: Cytokinmiljø

Hvad sker der ved signal 1: Antigengenkendelse? (Th)
1. TCR der sidder på Th cellen genkender et peptid der sidder bundet i kløften af MHC II på overfladen af en APC.
2. Signalet der sendes ind i cellen bliver medieret af CD3 komplekset
-CD3 indeholder proteinkinaser der kan fosforylere proteinkinaser
3. CD4 binder til MHC II og er med til og forstærke signalet
-PIP2 og IP3 hydrolyserer til DAG
4. Dette er med til at aktivere intracellulære signaler der er med til at øge T cellens proliferation.
5. Når Th cellen får signal 1, så udtrykker den CD40 der binder til CD40L på APC. Dette er med til at opregulere CD80/86 der skal anvendes til signal 2.

Hvad sker der ved signal 2: Kostimulation? (Th)
Signal 2 bliver medieret gennem CD28 på T cellens overflade.
1. CD28 på T cellens overflade reagerer med CD80/CD86 på APC'ens overflade.
2. Dette er med til og øge den intracellulære signalering.

Hvad sker der ved signal 3: Cytokinmiljø? (Th)
Efter at Th cellen er blevet aktiveret, så begynder den og prolifere.
Til hvilken form for T celle den prolifere til, bliver afgjort af det cytokin miljø at cellen befinder sig i, når den modtager signalerne.
Dette kaldes for signal 3.

Hvad sker der hvis Th cellen ikke modtager signal 1, 2 og 3?
Hvis cellen kun modtager signal 1, så vil den blive anergisk.
Modtager den signal 2 også, vil den aktiveres.
Modtager den signal 3 også, vil den differentiere videre til en specifik form for T celle.
Hvilke former for T celler kan den aktiverede T celle differentiere til?
Th1
Th2
Th17
iTreg
Hvad får cytokinet IFN-y, IL-2 og lymfotoksin cellen til at differentiere til?
Th1 celler

Hvad får cytokinet IL-4-6, 10, 13 og 21 cellen til at differentiere til?
Th2 celler

Hvad får cytokinet IL-17 cellen til at differentiere til?
Th17 celler

Hvad får cytokinet IL-10 og TGF-B cellen til at differentiere til?
Itreg

Beskriv kort de tre trin i aktiveringen af Tc celler
Signal 1: antigen genkendelse
-Tc cellen genkender peptider der sidder bundet på MHC I
-Der sendes signal gennem CD3 komplekset
Signal 2: Kostimulation
-CD8+ T celler kræver mere kostimulation end CD4+ celler.
-CD28 på T cellen reagere med CD80/86 på APC.
Signal 3: Cytokinmiljø
- Når Tc cellerne aktiveres, så udvikler de sig som regel til cytotoktiske effektor (Tc) celler
Hvilke cytokiner danner Tc cellen, og hvad gør dette?
IFN-y
Det opregulerer ekspressionen af MHC I
Hvad er en Th0 celle?
Det er en naiv T celle der endnu ikke har mødt sit antigen, og som under påvirkning af cytokinsignaler vil differentiere til en af de fire former for Th celler
-Th1
-Th2
-Th17
-Itreg
Beskriv Th1 celler, hvilke celler de har indvirkning på, og hvad deres vigtigste effekter er?
Har indvirkning på Makrofager og NK celler.
Står for cellemedieret immunitet.
Dræber intracellulære bakterier, samt celler der er inficeret med virus.
IFN-y aktiverer makrofager og hjælper med at opregulere MHC I og II.
Immunforsvar med Th 1 medfører at bakterier dræbes mere effekt.
Beskriv Th2 celler, hvilke celler de har indvirkning på, og hvad deres vigtigste effekter er?
Har indvirkning på eosinofile granulocytter og B celler
De spiller en vigtig rolle i cellemedieret immunitet.
De er med i forsvaret mod parasitter.
IL-4 spiller en vigtig rolle i immunglobulin skifte.
Beskriv Th17 celler, hvilke celler de har indvirkning på, og hvad deres vigtigste effekter er?
De har indvirkning på epithelceller og neutrofile granulocytter.
De spiller en vigtig og stor rolle i udviklingen af autoimmune sygdomme, da IL-17 danner kemokiner, cytokiner mm.
De ses også i forsvaret mod svampe, inflammation og øger rekrutteringen af neutrofile granulocytter.
Beskriv iTreg celler, hvilke celler de har indvirkning på, og hvad deres vigtigste effekter er?
De har indvirkning på B celler og T celler.
De er med til at dæmpe T celle responserne.
Hvad er regulatoriske T celler?
Det er en type CD4+ T celler der sender suprresive signaler til immunsystemet.
Der findes to typer af de regulatoriske T celler
- Naturlige (nTreg)
-Inducerbare (iTreg)

Beskriv iTreg
1. Forlader thymus som naive T celler og skal modnes i det lymfoide væv hvor de så kan udvikle sig til iTreg
2. Cellemarkør: FOXP3
3. Udskiller cytokinerne IL-10 og TGF-B der virker inhiberende på immunsystemet.

Beskriv nTreg
1. Forlader thymus som effektor celler
2. Cellemarkør: CD25 og FOXP3
3. De hæmmer immunceller og virker dermed immunsuprimerende
4. De kræver direkte kontakt med celler for at virke suprimerende.

Hvordan fungerer CD8+ T cellens dræberfunktion?
CD8+ T celler dræber kroppens egne celler hvis de er inficeret med vira eller cancer.
Hvad vil Tc celler (CD8+) dræbe, hvis de tidligere har været aktiveret?
Celler der fremviser MHC I
Gennem hvilke to former for celledød, dræber Tc cellerne?
1. Granula/exocytose (perforin/granzym) vejen
2. Fas/Fasl ligand vejen
Beskriv 'Granula/exocytose (perforin/granzym) vejen' hvor Tc celler inducerer celledød
1. Tc cellen genkender målcellen og danner en immunologisk synapse.
2. Tc cellen frigiver cytotoksiske granula ind i synapsen
3. Granulaen indeholder perforin der danner små porer i cellemembranen på målcellen.
4. Gennem perforin porrerne trænger serinproteaser ind til målcellens kerne og cytoplasma.
5. Granzym A og B kommer ind i målcellens kerne og inducerer apoptose.
Beskriv 'Fas/Fasl ligand vejen' hvor Tc celler inducerer celledød
1. Fas (CD95) er en dødsreceptorer der findes på en lang række celler.
2. Fas ligand, FasL (CD178) findes på Tc og NK celler.
3. Når FasL interagere med Fas på målcellens membran, så bevæger dødsdomænerne sig tættere sammen og binder til et protein der aktiverer caspasen.
4. Aktivering af caspase inducerer apoptose.
Hvad sker der med Tc cellerne når de har udøvet deres drabsmekanisme?
Tc cellen frigives fra synapsen med den døende celle og leder efter en ny målcelle den kan dræbe.
Hvilket molekyle er vigtig for at T celle proliferationen ophører igen?
CD152.
Det ligner CD28, og binder til CD80/86, men virker inhiberende på T cellen og gør at den stopprr med at dele sig.
Hvorfor udvikles memory celler?
For at give det adaptive immunsystem en hukommelse, så det hurtigere og bedre kan træde i kraft hvis organismen udsættes for samme antigen igen.
Hvordan dannes memory T celler?
De opstår ved kloneksspansion ved det primære immunrespons.
Når antigenet er blevet elimineret fra fra organismen, så ophører T cellernes proliferation.
Omkring 95% af de dannede T celler vil dø ved apoptose, de tilbagestående T celler er memory celler.
Hvilke former for memory celler findes der?
1. Effektor memory celler
2. Centrale memory celler
Hvilken overflademarkør bærer memory T celler?
CD45RA
Beskriv effektor memory celler
De har mistet kemokin receptoren CCR7
De har opreguleret deres ekspression af integriner.
De cirkulerer i kroppens væv og kan hurtig differentiere til effektor celler
Beskriv centrale memory celler
De har bevaret kemokin receptoren CCR7
De aktiveres ikke ligeså hurtig som effektor memory celler